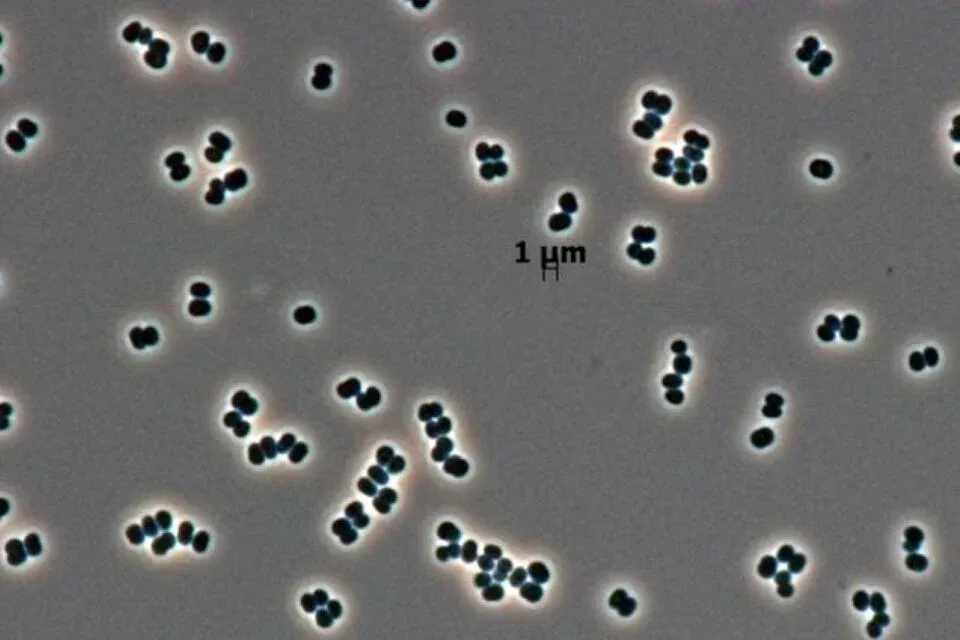

A legapróbb életformák néha a legerősebbek – bárhol és bármit túlélnek, mindent megtesznek az életben maradásért. És ez alkalmasint magában foglalja még a saját haláluk színlelését is.
2007-ben fedezett fel a NASA egy új baktériumot, a Tersicoccus phoenicist, amely két különálló tisztaszobában – szakszerűbben: tisztaterű szerelőcsarnokban – rejtőzött, egymástól 4000 kilométerre. Miután évekig nem értették, hogyan kerülhetett oda, az Environmental Microbiology-ban nemrég megjelent tanulmány végre választ ad a kérdésre: ez a baci (mikroorganizmus) téli álmot alszik – pontosabban tetszhalott állapotba kerül –, és azt „hiteti” el a tudósokkal, hogy halott.
Fotó: NASA/JPL-Caltech
„Nem halott. Csak úgy tesz, mintha az lenne” – mondja Madhan Tirumalai, a tanulmány vezető szerzője és a Houstoni Egyetem mikrobiológusa a National Geographicnak. „Holott csak szunnyad.”
Miért is kell tisztaszoba?
Nem mindegyik űrhajónak kell tökéletesen tisztának lennie; például egy távoli bolygók tanulmányozására vagy Föld-közeli aszteroidák keresésére tervezett űrteleszkóp küldetését egyetlen elkóborolt porszem vagy baktérium nem fogja kisiklatni.
De ha mondjuk egy olyan rovert építünk, amely földönkívüli mikrobák után kutat, akkor nagyon nem jó, hogy a Föld saját mikrobái zavarják össze a gyűjtött adatokat. Ahogy az űrhajósok is el akarják kerülni a találkozást a betegségeket okozó baktériumokkal, gombákkal, vírusokkal.
Ezért az egyes tisztaszobáknak – a tisztatereknek – rendkívül tisztáknak kell lenniük. Egy ilyen, mondjuk ISO 8-as osztályú helyiségben óránként akár 40-szer is kicserélik a szűrt, kondicionált levegőt. A helyiségben 20-30 Pascal túlnyomás uralkodik. Lézeres részecskeérzékelők figyelik, hogy percenként és köbméterenként legfeljebb 3 520 000 darab 0,5 µm-es és 29 300 darab 5 µm-es részecske legyen a levegőben.
A tudósok szigorú intézkedéseket alkalmaznak, beleértve az ismételt melegítést (hőkezelést), szárítást, a kémiai tisztítást mikrobaölő gázokkal, illetve ultraibolya- és sugárkezelést, hogy semmilyen élet ne maradjon a tisztaszobában.




















Szóljon hozzá!
Jelenleg csak a hozzászólások egy kis részét látja. Hozzászóláshoz és a további kommentek megtekintéséhez lépjen be, vagy regisztráljon!